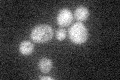
YKR054C
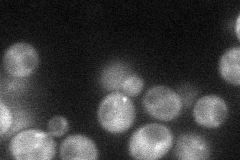
YKR054C
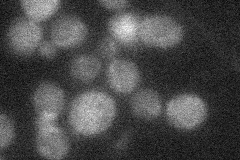
YKR054C
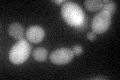
YKR054C
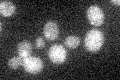
YKR054C

View description
Cytoplasmic heavy chain dynein, microtubule motor protein, required for anaphase spindle elongation; involved in spindle assembly, chromosome movement, and spindle orientation during cell division, targeted to microtubule tips by Pac1p
Localization:
Intensity:
Fold change:
Significance:
-
C’ GFP library in SD
below threshold19.67 -
N' NOP1pr-GFP in SD
punctate33.8528 -
N' TEF2pr-mCherry in SD

punctate13.4248 -
N' NATIVEpr-GFP in SD
below threshold21.9544 -
N' TEF2pr-VC and Cyto-VN in SD

#N/A0 -
C’ GFP library in SD+DTT
cytosol30.521.55No -
C’ GFP library in SD+H2O2

cytosol22.071.12No -
C’ GFP library in Starvation Media
cytosol19.140.97No -
C’ GFP library on the background of Pup2-DaMP

below threshold -
C’ GFP library on the background of CCT mutant

below threshold23.78791.20867No
